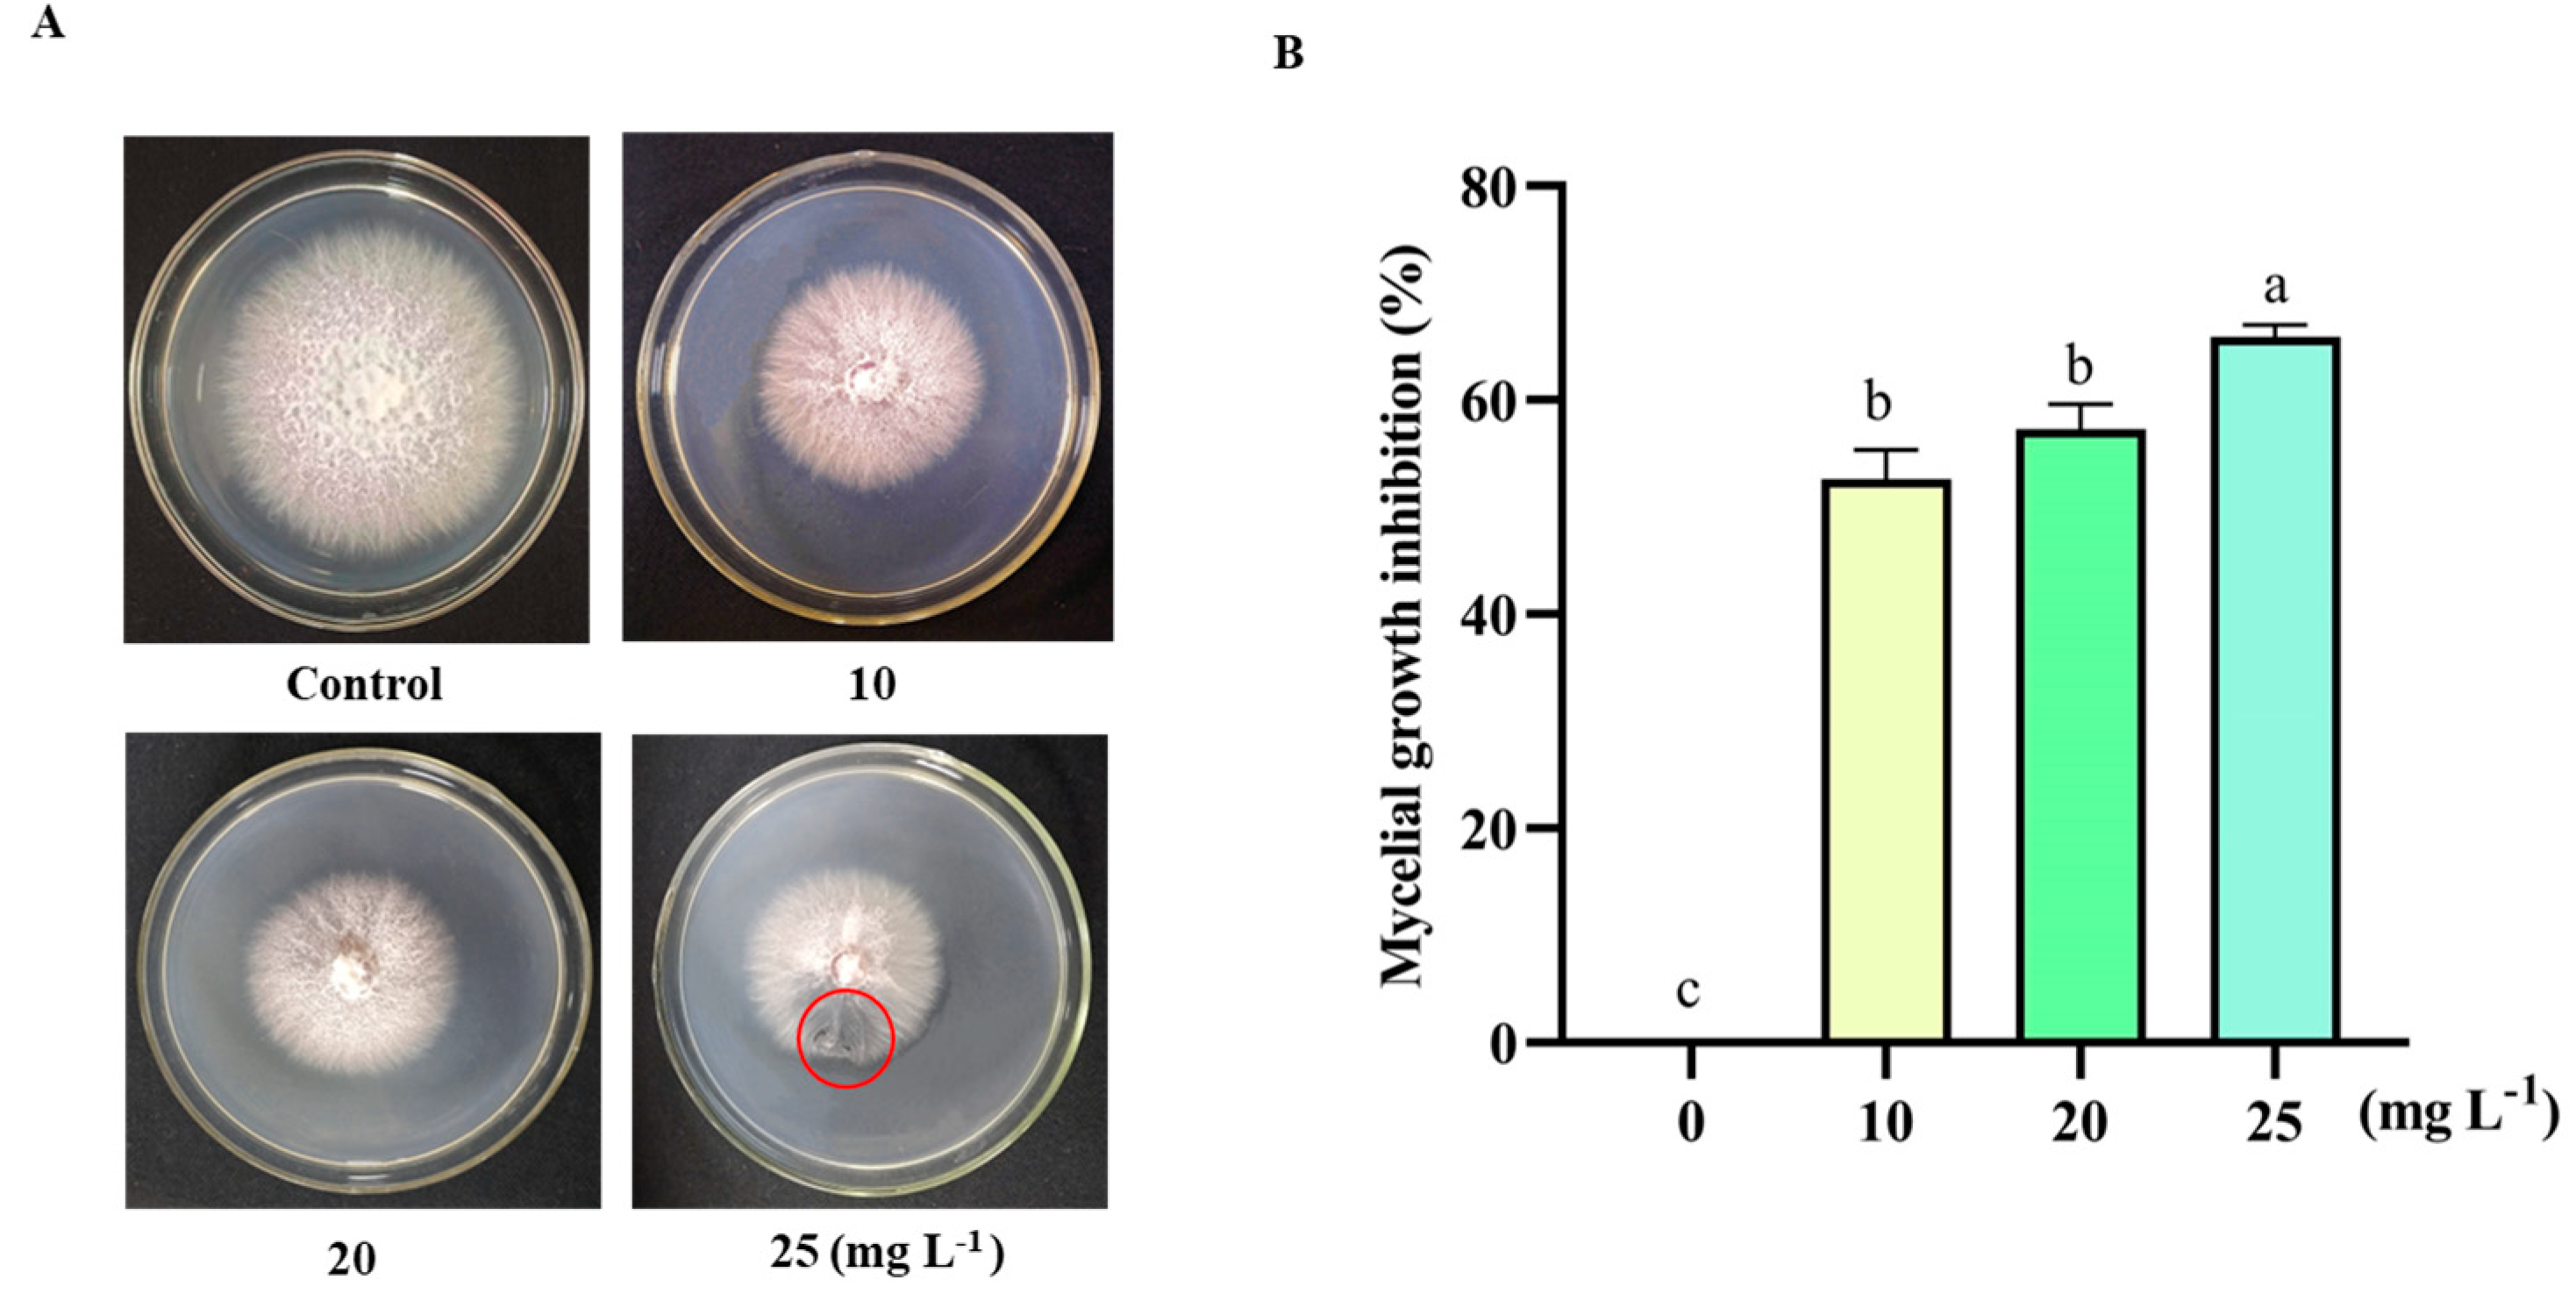
Agronomy 13 01210 g001

Application of 6-Pentyl-α-Pyrone in the Nutrient Solution Used in Tomato Soilless Cultivation to Inhibit Fusarium oxysporum HF-26 Growth and Development
Abstract
1. Introduction
2. Materials and Methods
2.1. Fungal Isolates and Plants
2.2. Collection of T. asperellum PT-15 Volatile Compounds and Gas Chromatography-Mass Spectrometry
2.2.1. Sample Extraction
2.2.2. Gas Chromatography Conditions
2.2.3. Mass Spectrometry Conditions
2.3. Effect of 6-PP on F. oxysporum HF-26 Mycelial Growth
2.4. Effect of 6-PP on F. oxysporum HF-26 Fusaric Acid Synthesis
2.5. Real-Time Quantitative Reverse Transcription Polymerase Chain Reaction
2.6. Greenhouse Experiments
2.7. Determination of Reactive Oxygen Species and the Activity of Defence-Related Enzymes and Genes
2.8. Statistical Analysis
3. Results
3.1. Analysis of VOCs Produced by T. asperellum PT-15
3.2. Effect of 6-PP on Inhibition of F. oxysporum HF-26 Growth
3.3. Effect of 6-PP on Pigments
3.4. Relative Expression Levels of Fusarium Acid Synthesis and Transport Genes
3.5. Effect of the Nutrient Solution Containing 6-PP on the Control of Tomato FW in Soilless Culture
3.6. Determination of Defence-Related Enzymes
3.7. Effect of Treatment with a Nutrient Solution Containing 6-PP on the Relative Expression of Defence-Related Genes
4. Discussion
5. Conclusions
Supplementary Materials
Author Contributions
Funding
Data Availability Statement
Acknowledgments
Conflicts of Interest
References
- Li, Q.S.; Li, X.Q.; Tang, B.; Gu, M.M. Growth responses and root characteristics of lettuce grown in aeroponics, hydroponics, and substrate culture. Horticulturae 2018, 4, 35. [Google Scholar] [CrossRef]
- Savvas, D.; Gianquinto, G.; Tuzel, Y.; Gruda, N. Soilless culture. In Good Agricultural Practices for Greenhouse Vegetable Crops; FAO—Plant Production and Protection Paper; The United Nations: Rome, Italy, 2013; p. 303. [Google Scholar]
- Gruda, N.S. Advances in soilless culture and growing media in today’s horticulture—An Editorial. Agronomy 2022, 12, 2773. [Google Scholar] [CrossRef]
- Song, W.T.; Zhou, L.G.; Yang, C.Z.; Cao, X.D.; Zhang, L.Q.; Liu, X.L. Tomato Fusarium wilt and its chemical control strategies in a hydroponic system. Crop Prot. 2004, 23, 243–247. [Google Scholar] [CrossRef]
- Segarra, G.; Casanova, E.; Avilés, M.; Trillas, I. Trichoderma asperellum strain T34 controls Fusarium wilt disease in tomato plants in soilless culture through competition for iron. Microb. Ecol. 2010, 59, 141–149. [Google Scholar] [CrossRef]
- Li, P.L.; Xie, X.W.; Shi, Y.X.; Li, B.J. Notes on Diagnosis by Dr. Li Po-ju (94) Attention to the control of fusarium wilt in cultivated vegetables in Northwest China. China Veg. 2016, 5, 85–87. [Google Scholar]
- Gilardi, G.; VasileiadouM, A.; Garibaldi, A.; Gullino, M.L. Biocontrol agents and resistance inducers reduce phytophthora crown rot (Phytophthora capsici) of sweet pepper in closed soilless culture. Phytopathol. Mediterr. 2021, 60, 149–163. Available online: http://digital.casalini.it/4981604 (accessed on 21 March 2023). [CrossRef]
- Fussy, A.; Papenbrock, J. An overview of soil and soilless cultivation techniques—Chances, challenges and the neglected question of sustainability. Plants 2022, 11, 1153. [Google Scholar] [CrossRef]
- Chatzivassiliou, E.K.; Livieratos, I.; Jenser, G.; Katis, N.I. Ornamental plants and thrips populations associated with tomato spotted wilt virus in Greece. Phytoparasitica 2000, 28, 257–264. [Google Scholar] [CrossRef]
- Schwarz, D.; Grosch, R. Influence of nutrient solution concentration and a root pathogen (Pythium aphanidermatum) on tomato root growth and morphology. Sci. Hortic. 2003, 97, 109–120. [Google Scholar] [CrossRef]
- El-Esawi, M.A.; El-Ballat, E.M.; Elsayed, A. Defensin treatment induces resistance to bacterial wilt of soilless-cultured tomato by regulating antioxidant mechanisms and genes expression. Egypt. J. Exp. Biol. 2022, 18, 75. [Google Scholar] [CrossRef]
- Gachango, E.; Kirk, W.; Schafer, R.; Wharton, P. Evaluation and comparison of biocontrol and conventional fungicides for control of postharvest potato tuber diseases. Biol. control. 2012, 63, 115–120. [Google Scholar] [CrossRef]
- Herrmann, A. (Ed.) The Chemistry and Biology of Volatiles, 1st ed.; John Wiley & Sons: Hoboken, NJ, USA, 2011; pp. 17–29. [Google Scholar]
- Hung, R.; Lee, S.; Bennett, J.W. Fungal volatile organic compounds and their role in ecosystems. Appl. Microbiol. Biotechnol. 2015, 99, 3395–3405. [Google Scholar] [CrossRef] [PubMed]
- Lemfack, M.C.; Gohlke, B.O.; Toguem, S.M.T.; Preissner, S.; Piechulla, B.; Preissner, R. mVOC 2.0: A database of microbial volatiles. Nucleic Acids Res. 2018, 46, D1261–D1265. [Google Scholar] [CrossRef] [PubMed]
- Morath, S.U.; Hung, R.; Bennett, J.W. Fungal volatile organic compounds: A review with emphasis on their biotechnological potential. Fungal Biol. Rev. 2012, 26, 73–83. [Google Scholar] [CrossRef]
- Ghazanfar, M.U.; Raza, M.; Raza, W.; Qamar, M.I. Trichoderma as potential biocontrol agent, its exploitation in agriculture: A review. Plant Prot. 2018, 2, 3. [Google Scholar]
- Gomes, E.N.; Elsherbiny, E.A.; Aleem, B.; Bennett, J.W. Beyond classical biocontrol: New perspectives on Trichoderma. Fungal Biotechnol. Bioeng. 2020, 19, 437–455. [Google Scholar]
- Korpi, A.; Järnberg, J.; Pasanen, A.L. Microbial volatile organic compounds. Crit. Rev. Toxicol. 2009, 39, 139–193. [Google Scholar] [CrossRef]
- Ma, Z.; Yao, G.; Wang, C. Study on α-pyrone derivatives from marine derived fungus Metarhizium sp. P2100. Chin. J. Mar. Drugs 2023, 42, 12–18. [Google Scholar]
- Picot, A.; Cobo-Díaz, J.F.; Pawtowski, A.; Donot, C.; Legrand, F.; Le Floch, G.; Déniel, F. Water Microbiota in Greenhouses with Soilless Cultures of Tomato by Metabarcoding and Culture-Dependent Approaches. Front. Microbiol. 2020, 11, 1354. [Google Scholar] [CrossRef]
- Hamrouni, R.; Molinet, J.; Dupuy, N.; Taieb, N.; Carboue, Q.; Masmoudi, A.; Roussos, S. The effect of aeration for 6-pentyl-alpha-pyrone, conidia and lytic enzymes production by Trichoderma asperellum strains grown in solid-state fermentation. Waste Biomass Valorization 2019, 11, 5711–5720. [Google Scholar] [CrossRef]
- Khan, R.A.A.; Najeeb, S.; Hussain, S.; Xie, B.; Li, Y. Bioactive Secondary Metabolites from Trichoderma spp. against Phytopathogenic Fungi. Microorganisms 2020, 8, 817. [Google Scholar] [CrossRef] [PubMed]
- Degani, O.; Gordani, A. New Antifungal Compound, 6-Pentyl-α-Pyrone, against the Maize Late Wilt Pathogen, Magnaporthiopsis maydis. Agronomy 2022, 12, 2339. [Google Scholar] [CrossRef]
- Stracquadanio, C.; Quiles, J.M.; Meca, G.; Cacciola, S.O. Antifungal activity of bioactive metabolites produced by Trichoderma asperellum and Trichoderma atroviride in liquid medium. J. Fungi 2020, 6, 263. [Google Scholar] [CrossRef]
- De la Cruz Quiroz, R.; Roussos, S.; Hernández, D.; Rodríguez, R.; Castillo, F.N.; Aguilar, N. Challenges and opportunities of the bio-pesticides production by solid-state fermentation: Filamentous fungi as a model. Crit. Rev. Biotechnol. 2015, 35, 326–333. [Google Scholar] [CrossRef] [PubMed]
- Li, W.; Chen, Z.H.; Meng, H.W.; Zhou, J.; Liang, J.; Liu, X.J. Effect of rotating different vegetables on micro-biomass and enzyme in tomato continuous cropped substrate and afterculture tomato under plastic tunnel cultivation. Acta Hortic. Sin. 2012, 1, 21. [Google Scholar]
- Liu, T.J.; Cheng, Z.H.; Meng, H.W.; Ahmad, I.; Zhao, H.L. Growth, yield and quality of spring tomato and physicochemical properties of medium in a tomato/garlic intercropping system under plastic tunnel organic medium cultivation. Sci. Hortic. 2014, 170, 159–168. [Google Scholar] [CrossRef]
- Lin, Y. Inhibitory Effect of Vinegar Grains Substrate on Soil-Borne Diseases and Its Antagonistic Microorganisms. Ph.D. Thesis, JianSu University, Zhenjiang, China, 2014. [Google Scholar]
- He, S.S. Preparation of Compound Bacteria for Biocontrol of Potato Verticillium Wilt. Ph.D. Thesis, Inner Mongolia Agricultural University, Hohhot, China, 2020. [Google Scholar]
- Deng, J.; Tian, Y.; Jiang, M.H.; Shang, B.H.; Li, Y.L.; Xiao, T.; Zhu, M.H.; Wang, K.B. Study on aroma components in different types of dark tea based on HS-SPME-GC-MS. Sci. Technol. Food Ind. 2023, 5, 1–12. [Google Scholar] [CrossRef]
- Niehaus, E.M.; von Bargen, K.W.; Espino, J.J.; Pfannmüller, A.; Humpf, H.-U.; Tudzynski, B. Characterization of the fusaric acid gene cluster in Fusarium fujikuroi. Appl. Microbiol. Biotechnol. 2014, 98, 1749–1762. [Google Scholar] [CrossRef]
- Wiemann, P.; Brown, D.W.; Kleigrewe, K.; Bok, J.W.; Keller, N.P.; Humpf, H.U.; Tudzynski, B. FfVel1 and FfLae1, components of a velvet-like complex in Fusarium fujikuroi, affect differentiation, secondary metabolism and virulence. Mol. Microbiol. 2010, 77, 972–994. [Google Scholar] [CrossRef]
- Limón, M.C.; Rodríguez-Ortiz, R.; Avalos, J. Bikaverin production and applications. Appl. Microbiol. Biotechnol. 2010, 87, 21–29. [Google Scholar] [CrossRef]
- Pfaffl, M.W. A new mathematical model for relative quantification in real-time RT-PCR. Nucleic Acids Res. 2001, 29, e45. [Google Scholar] [CrossRef]
- Hoagland, D.R.; Arnon, D.I. The water-culture method for growing plants without soil. In Circular; California Agricultural Experiment Station Circular: Davis, CA, USA, 1950; p. 347. [Google Scholar]
- Duan, Y.B.; Ge, C.Y.; Liu, S.G.; Chen, C.J.; Zhou, M.G. Effect of phenylpyrrole fungicide fludioxonil on morphological and physiological characteristics of Sclerotinia sclerotiorum. Pestic. Biochem. Physiol. 2013, 106, 61–67. [Google Scholar] [CrossRef]
- Wang, M.M. Effects of FUB4 and FUB11 Genes of Fusarium oxysporum f. sp. niveum on the Inhibition of Fusaric Acid Toxin Synthesis by Fuminic Acid and Its Function. Ph.D. Thesis, Northwest A&F University, Xianyang, China, 2022. [Google Scholar]
- Michielse, C.B.; Van, W.R.; Reijnen, L.; Manders, E.M.; Boas, S.; Olivain, C.; Rep, M. The nuclear protein Sge1 of Fusarium oxysporum is required for parasitic growth. PLoS Pathog. 2009, 5, e1000637. [Google Scholar] [CrossRef] [PubMed]
- López, B.M.S.; Hera, C.; Sulyok, M.; Schäfer, K.; Capilla, J.; Guarro, J.; Di, P.A. The velvet complex governs mycotoxin production and virulence of Fusarium oxysporum on plant and mammalian host. Mol. Microbiol. 2013, 87, 49–65. [Google Scholar] [CrossRef] [PubMed]
- Hao, J.; Wang, D.; Wang, Y.; Zhou, H. Attenuated Isolate Gibellulopsis nigrescens Vn-1 Enhances Resistance against Verticillium dahliae in Potato. Agronomy 2002, 12, 3082. [Google Scholar] [CrossRef]
- Miller, E.C.; Hadley, C.W.; Schwartz, S.J.; Erdman, J.W.; Boileau, T.W.M.; Clinton, S.K. Lycopene, tomato products, and prostate cancer prevention. Have we established causality? Pure Appl. Chem. 2002, 74, 1435–1441. [Google Scholar] [CrossRef]
- Antoszewski, M.; Mierek-Adamska, A.; Dąbrowska, G.B. The Importance of Microorganisms for Sustainable Agriculture—A Review. Metabolites 2022, 12, 1100. [Google Scholar] [CrossRef]
- Taha, M.A.; Ismaiel, A.A.; Ahmed, R.M. 6-pentyl-α-pyrone from Trichoderma koningii induces systemic resistance in tobacco against tobacco mosaic virus. Eur. J. Plant Pathol. 2021, 159, 81–93. [Google Scholar] [CrossRef]
- Phasha, M.M.; Wingfield, B.D.; Wingfield, M.J.; Coetzee, M.P.A.; Hammerbacher, A.; Steenkamp, E.T. Deciphering the effect of FUB1 disruption on fusaric acid production and pathogenicity in Fusarium circinatum. Fungal Biol. 2021, 125, 1036–1047. [Google Scholar] [CrossRef]
- Wang, R.; Leng, Y.; Shrestha, S.; Zhong, S. Coordinated and independent functions of velvet-complex genes in fungal development and virulence of the fungal cereal pathogen Cochliobolus sativus. Fungal Biol. 2016, 120, 948–960. [Google Scholar] [CrossRef]
- García-Villaraco, A.; Boukerma, L.; Lucas, J.A.; Gutierrez-Mañero, F.J.; Ramos-Solano, B. Tomato Bio-Protection Induced by Pseudomonas fluorescens N21.4 Involves ROS Scavenging Enzymes and PRs, without Compromising Plant Growth. Plants 2021, 10, 331. [Google Scholar] [CrossRef] [PubMed]

| Serial Number | Compound | Retention Time (min) | Area (%) | Molecular Formula | Molecular Weight |
|---|---|---|---|---|---|
| 1 | 1-Propanamine | 3.78 | 0.02 | C3H9N | 59.11 |
| 2 | 2-Methyl-pentanal | 4.06 | 1.28 | C6H12O | 100.16 |
| 3 | 2-Methyloctanal | 4.30 | 1.31 | C9H18O | 142.24 |
| 4 | Ethanol | 4.53 | 21.94 | C2H6O | 46.07 |
| 5 | Glycylglycine | 4.55 | 20.84 | C4H8N2O3 | 132.12 |
| 6 | Pentanal | 5.16 | 0.11 | C5H10O | 86.13 |
| 7 | 4-Hexyl-1,3-oxazolidin-2-one | 5.37 | 0.66 | C9H16NO2 | 170.23 |
| 8 | Ethyl propionate | 4.74 | 0.02 | C5H10O2 | 102.13 |
| 9 | Acetonitrile | 5.67 | 0.27 | C2H3N | 41.05 |
| 10 | N-Methyl-2-cyanopyrrole | 7.91 | 0.05 | C6H6N2 | 106.13 |
| 11 | N-Butyl propionate | 8.06 | 0.74 | C7H14O2 | 130.18 |
| 12 | 2-Propanone | 8.46 | 1.57 | C3H6O | 58.08 |
| 13 | 7,7-Dimethylcycloheptatriene | 8.60 | 6.46 | C9H12 | 120.19 |
| 14 | 8,9-Epithio-1-p-menthene | 8.96 | 0.00 | C10H16S | 168.3 |
| 15 | Methane-sulfonic anhydride | 9.28 | 0.02 | C2H6O5S2 | 174.2 |
| 16 | 3-Methyl-1-Butanol | 9.35 | 13.46 | C5H12O | 88.15 |
| 17 | Ethyl hexanoate | 9.70 | 0.04 | C8H16O2 | 144.21 |
| 18 | 1,2-Ethanediol,diethylether | 10.10 | 0.23 | C6H12O2 | 116.16 |
| 19 | (S)-1,1-Diethoxy-2-propanamine | 10.19 | 0.76 | C7H17NO2 | 147.13 |
| 20 | 3-Octanone | 10.22 | 4.26 | C8H16O | 128.21 |
| 21 | Styrene | 10.32 | 0.19 | C8H8 | 104.14 |
| 22 | Trans-β-methyl-styrene-α,β-d(2) | 10.57 | 0.07 | C9H8D2 | 120.19 |
| 23 | Acetoin | 10.83 | 0.17 | C4H8O2 | 88.11 |
| 24 | Propanoic acid | 11.09 | 0.14 | C3H6O2 | 74 |
| 25 | Tetradecane | 12.14 | 0.31 | C14H3O | 198.39 |
| 26 | Acetic acid | 13.19 | 0.05 | C2H4O2 | 61.04 |
| 27 | Ethanethioic acid S-ethyl ester | 13.26 | 0.08 | C4H8OS | 104.17 |
| 28 | 3-Furaldehyde | 13.39 | 0.09 | C5H4O2 | 96.08 |
| 29 | 3-Methyl Pentadecane | 14.46 | 0.04 | C16H34 | 226.44 |
| 30 | 9-Oxabicyclo[6.1.0]non-2-ene | 15.50 | 0.03 | C8H12O | 124.18 |
| 31 | 2-Phenylethanal | 15.52 | 0.01 | C8H8O | 120.15 |
| 32 | 1-Cyano-5-benzoyloxy-β-D-ribofuranose | 15.84 | 0.16 | C13H13NO5 | 263.25 |
| 33 | Hexacosane | 16.11 | 0.05 | C26H54 | 366.71 |
| 34 | 1-Eicosanol | 16.25 | 0.04 | C20H42O | 298.55 |
| 35 | 3-Methylthio propanol | 16.46 | 0.02 | C4H10OS | 106.19 |
| 36 | Chavicol | 16.52 | 0.02 | C9H10O | 134.18 |
| 37 | Methoxy-phenyl-Oxime | 16.65 | 0.08 | C8H9NO2 | 151.16 |
| 38 | Naphthalene | 16.96 | 0.07 | C10H8 | 128.18 |
| 39 | Isophthalaldehyde | 17.78 | 0.06 | C8H6O2 | 134.13 |
| 40 | 2,3-diethoxybutane | 17.89 | 0.03 | C8H18O2 | 146.23 |
| 41 | 2-Methyl-Naphthalene | 18.15 | 0.01 | C11H10 | 142.2 |
| 42 | Methylnaphthalene | 18.24 | 0.02 | C11H10 | 142.2 |
| 43 | Phenylethyl Alcohol | 18.68 | 0.63 | C8H10O | 122.18 |
| 44 | 2,5-Furandicarboxaldehyde | 19.51 | 0.02 | C6H4O3 | 124.09 |
| 45 | 2-Methyl-butane | 20.70 | 0.03 | C5H12 | 72.15 |
| 46 | 3-Carbamoyl phthalide | 21.13 | 0.01 | C9H7NO3 | 177.16 |
| 47 | 6 amyl α pyrone | 21.51 | 0.65 | C10H14O2 | 166.22 |
| 48 | 1-(2,4-dimethylphenyl)-Ethanone | 22.07 | 0.03 | C10H12O | 148.2 |
| 49 | 2,3-Dihydro-3,5-dihydroxy-6-methyl-4H-Pyran-4-one | 22.25 | 0.04 | C6H8O4 | 144.12 |
| 50 | 2-(4-fluoro-3-methoxycarbonylphenyl)-4-Nitrobenzoic acid | 22.56 | 0.01 | C15H10FNO6 | 319.24 |
| 51 | 5-Hydroxymethylfurfural | 24.68 | 0.13 | C6H6O3 | 126.11 |
| 52 | Cis-3-acetoxy-4-ethoxycarbonylamino-1-thia-cyclopentane | 25.69 | 0.02 | C9H15NO4S | 233.28 |
| 53 | 1-Methoxy-2-ethoxycyclobutanone | 26.12 | 0.06 | C7H12O3 | 144.17 |
| 54 | 4,4-Dimethyl-5-(1-methylene-2-phenyl-2-propenyl)-1,3-dioxolan-2-one | 27.26 | 0.07 | C15H16O3 | 244.29 |
| 55 | Methyl 1,3-dihydro-2H-isobenzofuran-4-carboxylate | 27.54 | 0.13 | C10H10O3 | 178.19 |
| Nutrient Solution | Concentration in Soilless Culture Nutrition | Disease Index (%) | Efficacy (%) |
|---|---|---|---|
| Containing 6-PP | 25 mg/mL | 27.23 ± 1.23 b | 70.71 ± 1.31 a |
| Containing carbendazim | 25 mg/mL | 29.98 ± 1.04 b | 70.96 ± 1.01 a |
| Common | —— | 92.98 ± 1.16 a | —— |
Disclaimer/Publisher’s Note: The statements, opinions and data contained in all publications are solely those of the individual author(s) and contributor(s) and not of MDPI and/or the editor(s). MDPI and/or the editor(s) disclaim responsibility for any injury to people or property resulting from any ideas, methods, instructions or products referred to in the content. |
© 2023 by the authors. Licensee MDPI, Basel, Switzerland. This article is an open access article distributed under the terms and conditions of the Creative Commons Attribution (CC BY) license (https://creativecommons.org/licenses/by/4.0/).
Share and Cite
Hao, J.; Wuyun, D.; Xi, X.; Dong, B.; Wang, D.; Quan, W.; Zhang, Z.; Zhou, H. Application of 6-Pentyl-α-Pyrone in the Nutrient Solution Used in Tomato Soilless Cultivation to Inhibit Fusarium oxysporum HF-26 Growth and Development. Agronomy 2023, 13, 1210. https://doi.org/10.3390/agronomy13051210
Hao J, Wuyun D, Xi X, Dong B, Wang D, Quan W, Zhang Z, Zhou H. Application of 6-Pentyl-α-Pyrone in the Nutrient Solution Used in Tomato Soilless Cultivation to Inhibit Fusarium oxysporum HF-26 Growth and Development. Agronomy. 2023; 13(5):1210. https://doi.org/10.3390/agronomy13051210
Chicago/Turabian StyleHao, Jianxiu, Dalai Wuyun, Xianmei Xi, Baozhu Dong, Dong Wang, Wei Quan, Ziyu Zhang, and Hongyou Zhou. 2023. "Application of 6-Pentyl-α-Pyrone in the Nutrient Solution Used in Tomato Soilless Cultivation to Inhibit Fusarium oxysporum HF-26 Growth and Development" Agronomy 13, no. 5: 1210. https://doi.org/10.3390/agronomy13051210
APA StyleHao, J., Wuyun, D., Xi, X., Dong, B., Wang, D., Quan, W., Zhang, Z., & Zhou, H. (2023). Application of 6-Pentyl-α-Pyrone in the Nutrient Solution Used in Tomato Soilless Cultivation to Inhibit Fusarium oxysporum HF-26 Growth and Development. Agronomy, 13(5), 1210. https://doi.org/10.3390/agronomy13051210

